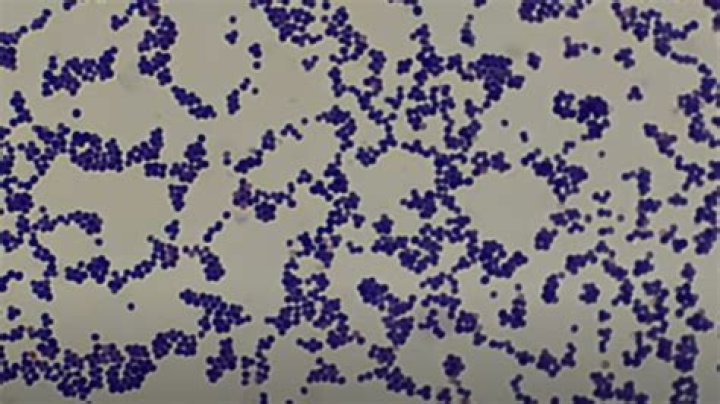

What disease does Streptococcus salivarius cause

Sarah Rodriguez
Published Apr 11, 2026
As recently underscored by the Centers for Disease Control and Prevention, S. salivarius and other viridans group streptococci are the most frequent causes of bacterial meningitis following spinal procedures such as anesthesia, accounting for up to 60% of cases [12].
Does Streptococcus salivarius cause strep?
Some strains of S. salivarius are found to produce BLIS (Bacteriocin-like Inhibitory Substances) which are antimicrobial peptides. These peptides display interspecies inhibition, and inhibit Streptococcus pyogenes (which causes strep throat infections).
How is Streptococcus salivarius transmitted?
It can be transmitted by direct contamination of sterile body fluid, for example, contamination of cerebrospinal fluid following epidural anaesthesia or lumbar puncture 4, 5, 9, 10, 14, due to contaminated equipment, by migration of the organism from the patient’s skin along the outer surface of the catheter 4, 5, 9, …
Where is Streptococcus salivarius found in the body?
Streptococcus salivarius is a gram-positive, facultative anaerobic microorganism that is found in the oral cavity and upper respiratory tract of human beings.How does Streptococcus salivarius benefit humans?
Influence of Streptococcus salivarius probiotics in the oral cavity. Health benefits can occur through the direct inhibition and exclusion of pathogens, modulation of the human immune system to reduce pathogen-induced inflammation or by ‘priming’ the immune system to respond rapidly to viral or bacterial infection.
What is Streptococcus salivarius Vestibularis?
S. salivarius and S. vestibularis are commensal organisms that may occasionally cause opportunistic infections in humans, whereas S. thermophilus is a food bacterium widely used in dairy production.
What does Streptococcus sanguinis cause?
Streptococcus sanguinis (S. sanguinis) is an abundant oral commensal which can cause disseminated human infection if it gains access to the bloodstream. The most important among these diseases is infective endocarditis (IE).
Does Streptococcus salivarius form spores?
It tests negative for cytochrome, oxidase, and catalase, and positive for alpha-hemolytic activity. It is non-motile and does not form endospores.Is Streptococcus salivarius beta hemolytic?
Thirty strains of Streptococcus salivarius were beta-haemolytic when initially isolated from throat swabs and, because they were also bacitracin sensitive, they could be confused with the pathogenic Streptococcus pyogenes on primary culture plates.
Is Streptococcus salivarius a probiotic?Streptococcus salivarius K12 is an oral probiotic strain releasing two lantibiotics (salivaricin A2 and salivaricin B) that antagonize the growth of S. pyogenes, the most important bacterial cause of pharyngeal infections in humans also affected by episodes of acute otitis media.
Article first time published onWhat is Streptococcus salivarius K12?
Background: Streptococcus salivarius K12 is an oral probiotic strain releasing two lantibiotics (salivaricin A2 and salivaricin B) that antagonize the growth of S. pyogenes, the most important bacterial cause of pharyngeal infections in humans also affected by episodes of acute otitis media.
What type of blood hemolysis does Streptococcus mutans exhibit?
Streptococcus mutans is normally alpha- or gamma-hemolytic on blood agar plates. However, three recently isolated S. mutans strains were observed to elicit beta-hemolysis. The production and nature of a hemolytic substance were studied.
Is Streptococcus salivarius positive or negative?
Streptococcus salivarius, a gram-positive bacterium found in the human oral cavity, expresses flexible peritrichous fimbriae.
What is the colony morphology of Streptococcus salivarius?
Fermentation Tests Text:Sorbitol : -,Sucrose : +Colony Appearance Text:smooth : Yes,shiny : YesColony Color Text:grey : YesColony Text:circular : Yes,convex : Yes,entire : YesColony Diameter:?
What causes Streptococcus anginosus?
It is most frequently caused by S. aureus (and sometimes by Staphylococcus lugdunensis and Staphylococcus capitis) followed by certain streptococci of the Streptococcus milleri group (Streptococcus constellatus, Streptococcus anginosus and Streptococcus intermedius) and enterococci.
Is Streptococcus sanguinis beta hemolytic?
Gram-positive microorganisms are responsible for the majority of cases of infective endocarditis. They include (1) streptococci, particularly viridans streptococci (e.g., Streptococcus sanguis, S. mutans, S. mitis); β-hemolytic streptococci (e.g., S.
Which of the following are types of infections caused by S agalactiae?
S agalactiae may cause meningitis, neonatal sepsis, and pneumonia in neonates; adults may experience vaginitis, puerperal fever, urinary tract infection, skin infection, and endocarditis.
What is infective endocarditis?
Infective endocarditis (IE) is an infection of the inner lining of the heart muscle (endocardium) caused by bacteria, fungi, or germs that enter through the bloodstream.
Is Streptococcus salivarius a lactic acid bacteria?
Starter Lactic Acid Bacteria. For the original Emmentaler Switzerland PDO, undefined strain mixtures of thermophilic lactic acid bacteria of the species Streptococcus salivarius subsp. thermophilus and Lactobacillus delbrueckii subsp. lactis isolated in the PDO region are used as a starter.
What foods contain Streptococcus salivarius?
They’re found naturally in fermented foods like kimchee, sauerkraut or kefir, and added during the manufacturing process into some dairy products, cereals, juice, baked foods and fermented meats, like sausage.
Is Strep pyogenes Gram positive?
Streptococci are gram-positive, catalase-negative, coagulase-negative cocci that occur in pairs or chains. They are divided into three groups by the type of hemolysis on blood agar: beta-hemolytic (complete lysis of red cells), a hemolytic (green hemolysis), and gamma-hemolytic (no hemolysis).
What are the diseases associated with Streptococcus?
- Strep Throat.
- Scarlet Fever.
- Impetigo.
- Necrotizing Fasciitis.
- Cellulitis.
- Streptococcal Toxic Shock Syndrome.
- Rheumatic Fever.
- Post-Streptococcal Glomerulonephritis.
How is Streptococcus different from enterococcus?
It is generally accepted that the enterococci and the non-enterococcal group D streptococci have the same LTA antigen which cross-reacts. The only recognized difference is that the non- enterococcal species contain relatively small amounts of the antigen.
Is Staph aureus beta-hemolytic?
Staphylococcus aureus is a common pathogen causing both hospital and community-acquired infections. Hemolysin is one of the important virulence factors for S. aureus and causes the typical β-hemolytic phenotype which is called complete hemolytic phenotype as well.
Is Strep pneumoniae beta hemolytic?
Streptococcus pneumoniae, or pneumococcus, is a Gram-positive, spherical bacteria, alpha-hemolytic (under aerobic conditions) or beta-hemolytic (under anaerobic conditions), aerotolerant anaerobic member of the genus Streptococcus. They are usually found in pairs (diplococci) and do not form spores and are non motile.
Which toxin of streptococcus causes hemolysis?
Extracellular products and toxins S pyogenes elaborates 2 distinct hemolysins. These proteins are responsible for the zone of hemolysis observed on blood agar plates and are also important in the pathogenesis of tissue damage in the infected host.
Is staph or strep catalase positive?
Staphylococcus and Micrococcus spp. are catalase positive, whereas Streptococcus and Enterococcus spp. are catalase negative. If a Gram-positive cocci is catalase positive and presumed to be a staphylococci, the coagulase test is often performed.
What is K12 and M18?
Both BLIS K12™ and BLIS M18™ are specific strains of Streptococcus salivarius but they work to do different things. For example, we know that BLIS K12™ can help support upper respiratory health, throat health and bad breath*. BLIS M18™, on the other hand help support teeth and gum health*.
What probiotic has Streptococcus?
Streptococcus thermophilus 19 is one of the most well-studied probiotics, which is selected in this study among seven strains isolated from homemade yogurt due to its optimal ability of suppressing the inflammation response in vitro.
What is K12 used for?
Streptococcus salivarius K12 (isolated from the saliva of a healthy child) is a probiotic intended for use in the oral cavity. Strain K12 has had a 5-year history of commercial application as a probiotic in New Zealand, with approximately 150,000 doses administered to date.
What is a probiotic culture?
Living microorganisms found in yogurt and other cultured foods may help improve your body’s bacterial environment inside and out. They’re called probiotics, a name that means “for life.” More and more people are using probiotic products to treat or improve illnesses or to maintain overall well-being.



